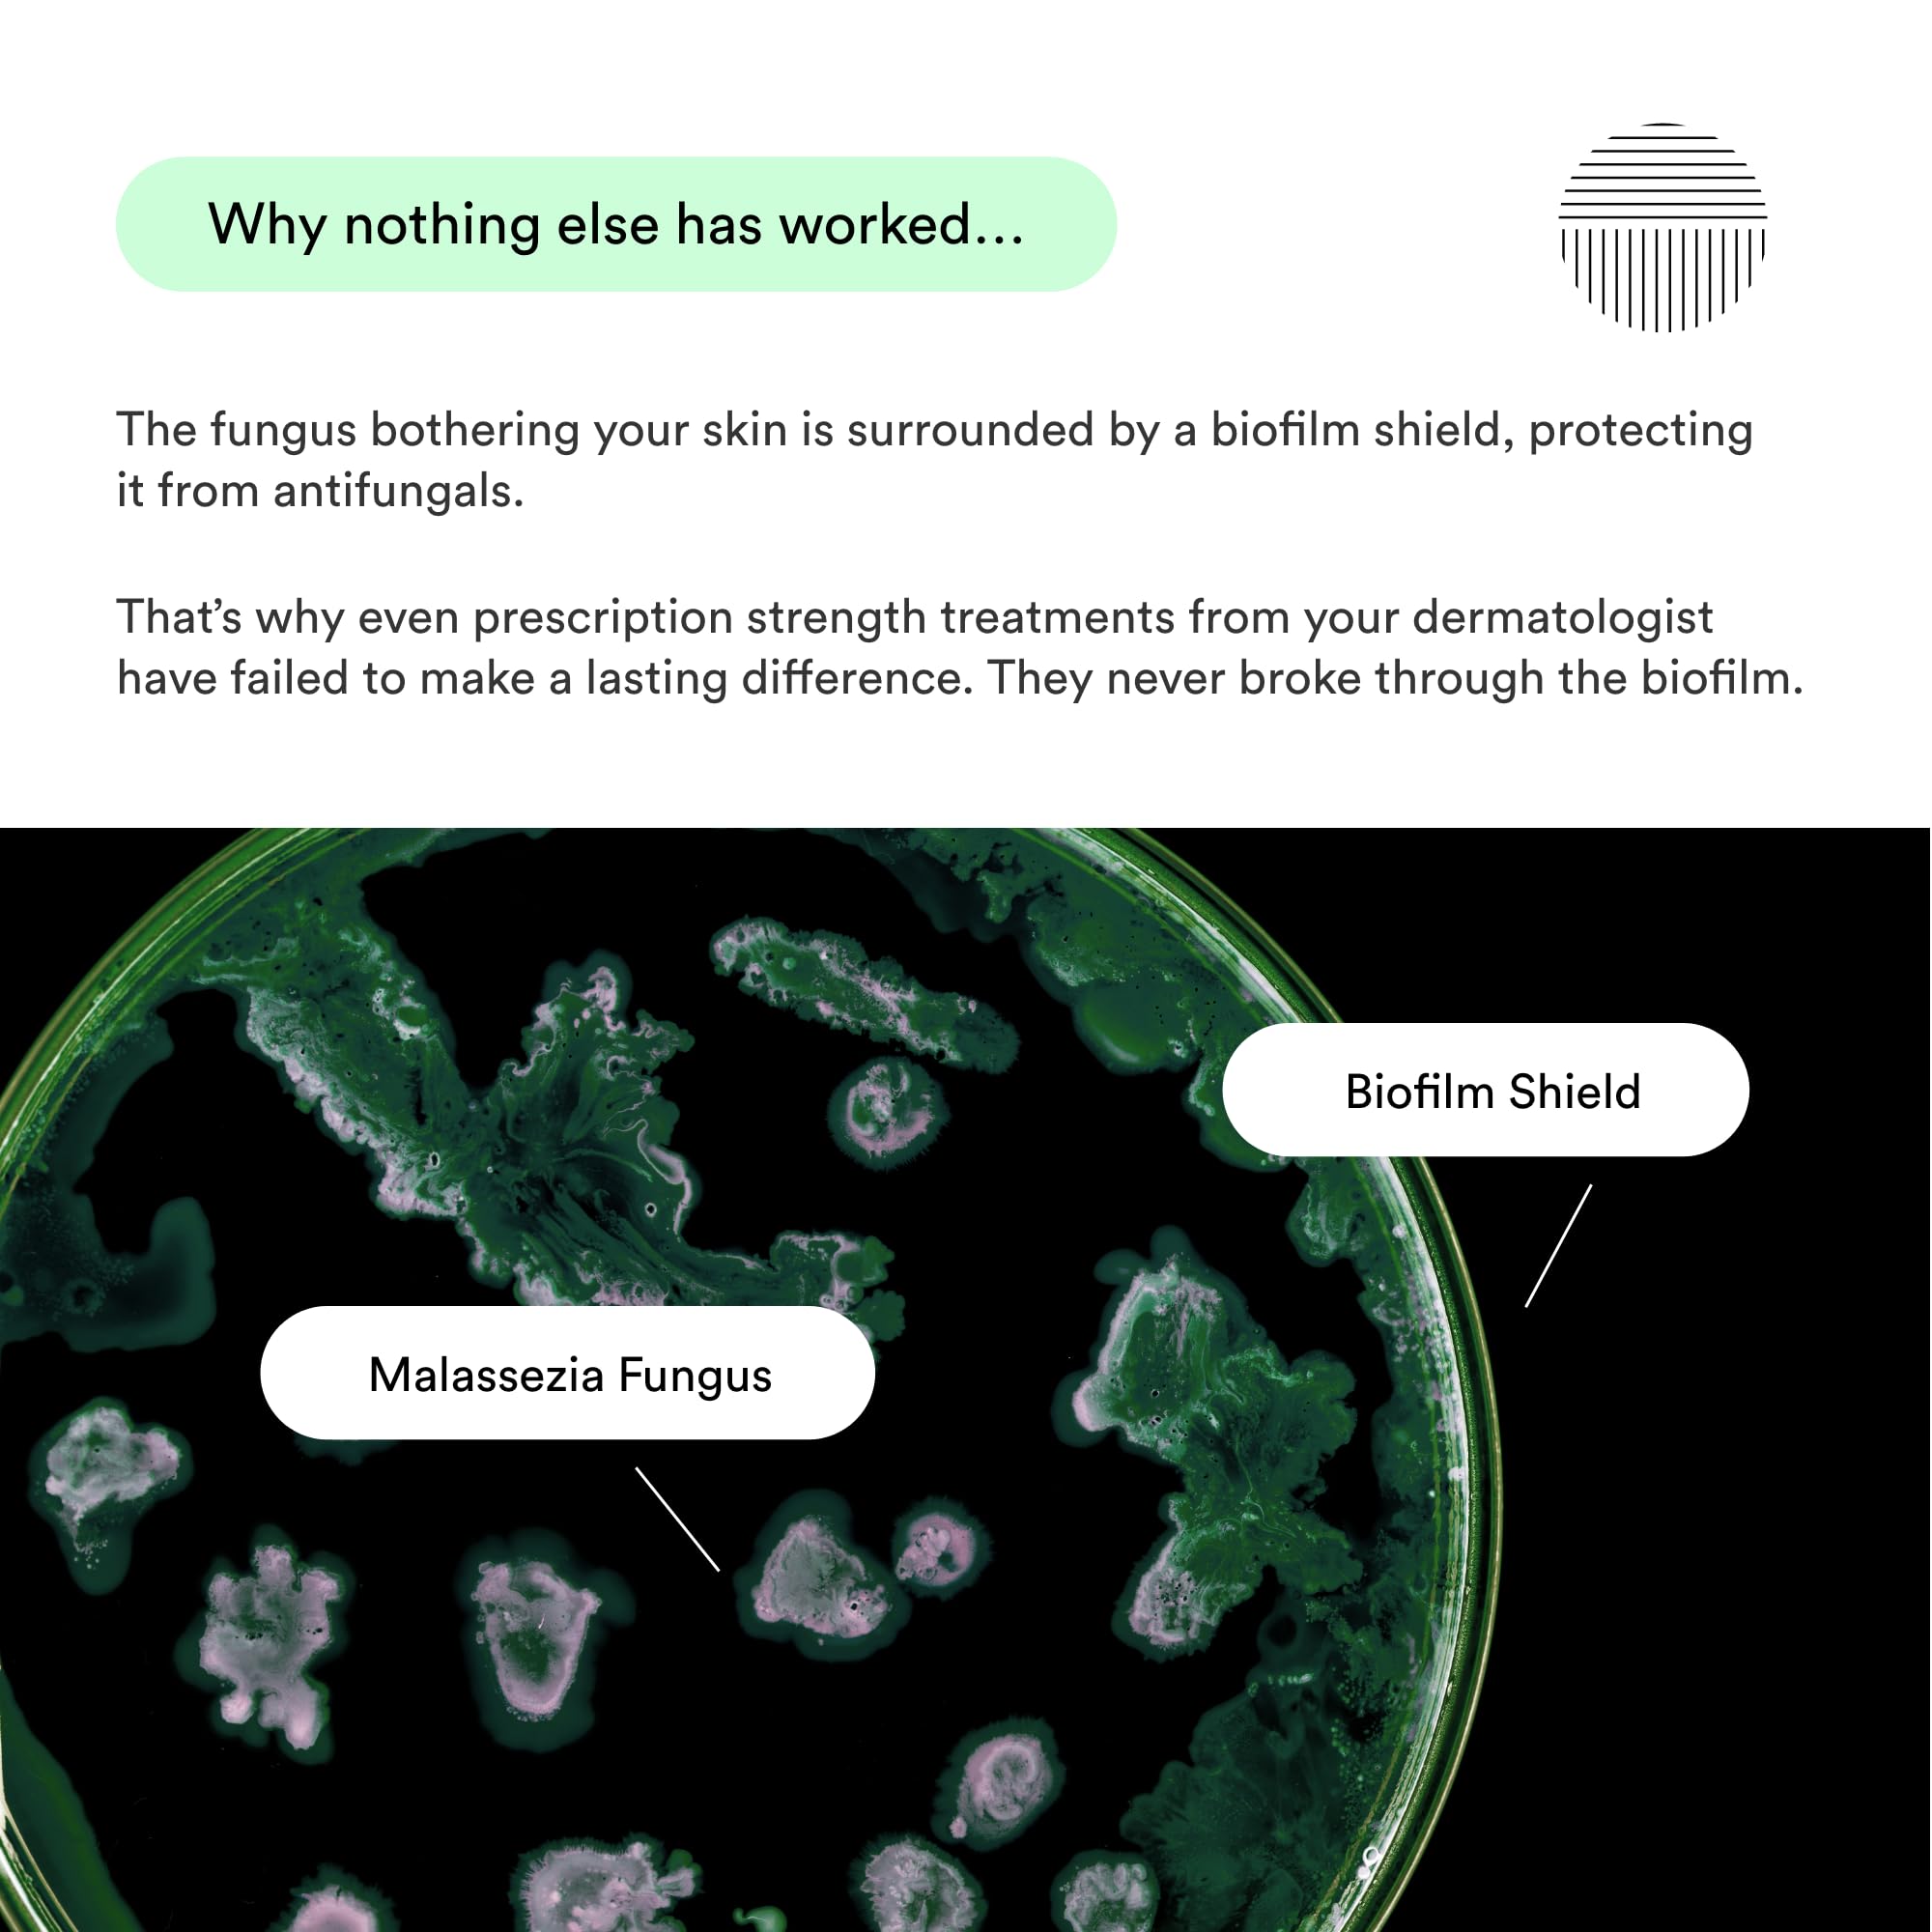
Thumbnail 9

🌿 Nourish your scalp, fuel your confidence — the ultimate dry scalp solution!
Dermazen Malassezia-Safe MCT Scalp Moisturizer is a 4oz natural treatment designed to hydrate, soothe, and protect dry, flaky scalps. Featuring a unique MCT oil blend free of lauric acid, it starves Malassezia yeast while nourishing with tea tree and rosemary essential oils. This formula relieves itchiness, reduces flakes, and supports hair growth by improving scalp health, making it ideal for men and women seeking a balanced, healthy scalp.





| Manufacturer | Dermazen | 
| Package Dimensions | 10.16 x 5.08 x 5.08 cm; 113.4 g | 
| ASIN | B0DBSWLKXV | 
Trustpilot
2 weeks ago
2 weeks ago